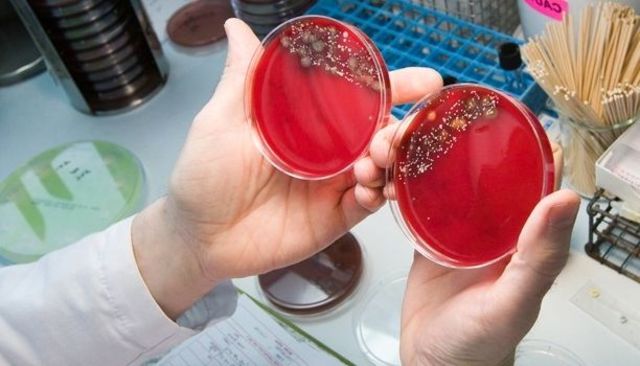
Microbiología en México

Línea de tiempo acerca de la carrera de Químico Bacteriólogo Parasitólogo
-
Zacharias Janssen creó el primer microscopio compuesto. Tenía los lentes en cada extremo de manera que al ser visto un objeto a través de este, el objeto aparecería grandemente aumentado.
-
Robert Hook observa la primera célula.
-
Anton van Leeuwenhoek mejoró la calidad de los microscopios mediante el desarrollo de técnicas especiales para pulir lentes.
-
Primeras observaciones descritas por Anton van Leeuwenhoek realizadas con microscopios caseros de microorganismos de agua de lluvia.
-
Crea vacuna contra la viruela
-
Comprobó que el tratamiento térmico repetido permitía evitar el crecimiento de microorganismos en infusiones. Este personaje supone un primer desarrollo de métodos de esterilización de líquidos.
-
Demuestran el origen microbio de procesos de fermentación láctica, alcohólica, mediante experimentos.
-
Robert Koch descubrió que la M. tueberculosis podía cultivarse en suero de sangre coagulada. Mediante esto su estudio demostró que era el agente causal de la tuberculosis.
-
Ziehl y Neelsen desarrollan el método de ácido-alcohol resistencia para teñir Mycobacterium tuberculosis.
-
Este bacteriologo que desarrolló la tinción de Gram, de amplio uso en microbiología.
-
Theodor Escherich Inicialmente se dedicó al estudio de la bacteriología y en este año descubre la Escherichia coli
-
Introduce el uso de cajas petri en la microbiología
-
Se dio inicio de la cátedra de Bacteriología en la Escuela de Medicina, a cargo de Ángel Gaviño , asimismo se creó el Instituto Médico Nacional.
-
Llego a la separación de la sección de bacteriología para dar origen al Instituto Bacteriológico.
-
Descubre la penicilina
-
El Dr. Eduardo Aguirre Pequeño funda la facultad de Ciencias Biológicas bajo el amparo del Instituto de Investigaciones Científicas
-
Se establece un nuevo plan de estudios de Biólogo Bacteriólogo Parasitólogo
-
La carrera de Biólogo Bacteriólogo Parasitólogo es modificada a Químico Bacteriólogo Parasitólogo.
-
Niels Jerne, Georges Köhler y César Milstein trabajaron en el sistema inmunitario y en la producción de anticuerpos monoclonales.
Plan projects on a visual timeline
Map milestones, phases, deadlines, and key events in one place so the sequence is easier to see and share. Timetoast is a timeline maker for work, school, research, and stories.